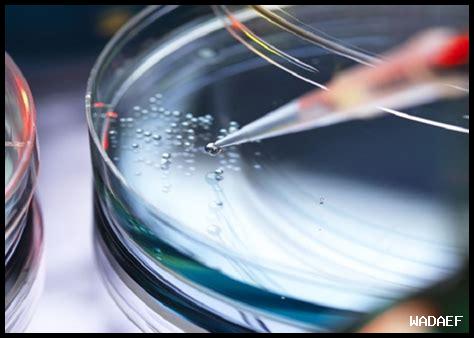
كيف تؤثر سكاكر سكلتس المجففة بالتجميد على الوزن

كيف تؤثر سكاكر سكلتس المجففة بالتجميد على الوزن
تعتبر سكاكر سكلتس المجففة بالتجميد من الحلويات المحبوبة لدى الكثيرين، حيث تتميز بمذاقها الفريد وقوامها المقرمش. ولكن، هل تساءلت يومًا عن تأثير هذه السكاكر على الوزن؟ في هذا المقال، سنستعرض كيف تؤثر سكاكر سكلتس المجففة بالتجميد على الوزن، مع التركيز على الفوائد والمخاطر المحتملة.
ما هي سكاكر سكلتس المجففة بالتجميد؟
تُعتبر سكاكر سكلتس المجففة بالتجميد نوعًا من الحلويات التي يتم إنتاجها من خلال عملية تجفيف خاصة تُعرف بالتجميد. هذه العملية تحافظ على النكهة والقوام، مما يجعلها خيارًا شائعًا بين محبي الحلويات.
فوائد سكاكر سكلتس المجففة بالتجميد
- تحتوي على سعرات حرارية منخفضة مقارنةً بالحلويات التقليدية.
- تحتوي على مكونات طبيعية، مما يجعلها خيارًا صحيًا أكثر.
- تساعد في إشباع الرغبة في تناول الحلويات دون زيادة الوزن بشكل كبير.
كيف تؤثر سكاكر سكلتس على الوزن؟
التأثير الإيجابي
من ناحية أخرى، يمكن أن تؤثر سكاكر سكلتس المجففة بالتجميد بشكل إيجابي على الوزن إذا تم تناولها باعتدال. حيثما يتم استهلاكها كجزء من نظام غذائي متوازن، يمكن أن تساعد في تقليل الرغبة في تناول الحلويات ذات السعرات الحرارية العالية.
التأثير السلبي
على سبيل المثال، إذا تم تناول سكاكر سكلتس بكميات كبيرة، فقد يؤدي ذلك إلى زيادة الوزن.
. علاوة على ذلك، تحتوي بعض الأنواع على مكونات إضافية مثل السكر أو المواد الحافظة، مما قد يزيد من السعرات الحرارية.
نصائح لتناول سكاكر سكلتس بشكل صحي
للحفاظ على وزن صحي، إليك بعض النصائح لتناول سكاكر سكلتس المجففة بالتجميد:
- تناولها كوجبة خفيفة بين الوجبات الرئيسية.
- اختر الأنواع التي تحتوي على مكونات طبيعية وبدون إضافات غير صحية.
- راقب الكمية التي تتناولها، حيث أن الاعتدال هو المفتاح.
الخلاصة
في النهاية، يمكن القول إن سكاكر سكلتس المجففة بالتجميد يمكن أن تكون خيارًا جيدًا إذا تم تناولها بشكل معتدل. كما أن فهم تأثيرها على الوزن يساعد في اتخاذ قرارات غذائية أفضل. بناءً على ذلك، يجب أن تكون واعيًا لاختياراتك الغذائية وأن تحرص على تناولها كجزء من نظام غذائي متوازن.
للمزيد من المعلومات حول تأثير الحلويات على الوزن، يمكنك زيارة ويكيبيديا أو الاطلاع على الموارد الحكومية.
إذا كنت تبحث عن المزيد من المعلومات حول التغذية والوزن، يمكنك زيارة موقع وادف.